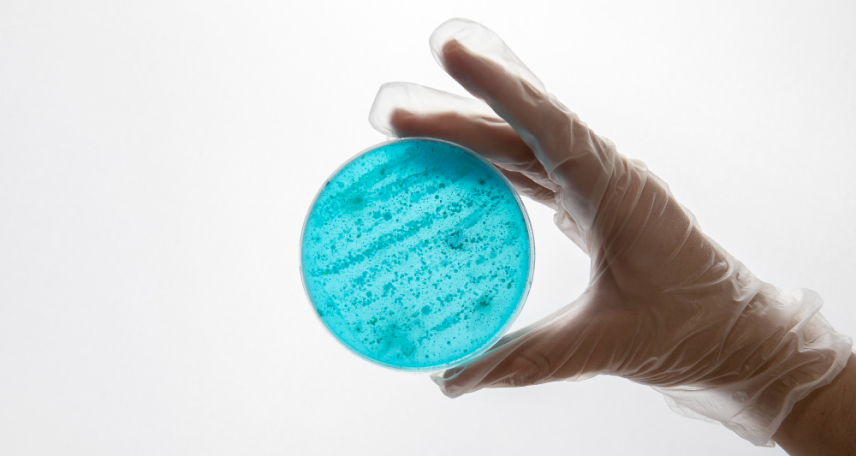
Rapid Micro Methods (RMM) in EM in the Pharmaceutical Cleanroom Industry

by Vaibhavi M.
null minutes
Rapid Micro Methods (RMM) in EM in the Pharmaceutical Cleanroom Industry
Explore how RMM brings faster, compliant, and real-time microbial detection to pharma cleanrooms.
Environmental Monitoring (EM) is a foundation stone of contamination control in pharmaceutical cleanrooms. Traditionally, it has relied on culture-based methods such as settle plates, contact plates, and active air samplers, all of which require incubation periods of several days before results are available. However, as regulatory expectations evolve and manufacturing timelines compress, the industry is turning to Rapid Microbiological Methods (RMM) to gain faster and more reliable insight into microbial contamination.
RMM technologies are revolutionising the monitoring of cleanroom environments, enabling real-time or near-real-time detection, reducing delays in product release, and supporting data-driven decision-making within contamination control strategies.
Understanding RMM in the Context of Environmental Monitoring
RMM refers to analytical techniques that accelerate or automate the detection, enumeration, or identification of microorganisms, compared to conventional culture-based methods. Within the pharmaceutical cleanroom context, RMM can be applied to:
- Air and surface monitoring
- Water and utility system testing
- Personnel monitoring
- Product bioburden and sterility testing
In EM specifically, RMM aims to replace or complement traditional incubation-based tests with technologies that detect microbial contamination more rapidly, sometimes in hours or even minutes.
The Regulatory Perspective: 21 CFR Part 11 and Annex 1 Alignment
Modern RMM systems are not only about speed but also about data integrity and compliance. Regulatory frameworks such as 21 CFR Part 11 (FDA) and Annex 1 (EU GMP) emphasize electronic data capture, traceability, and validated automated systems.
The revised Annex 1 (2022) explicitly encourages the use of modern technologies to improve contamination control, stating that “rapid methods should be considered where they provide an advantage over traditional methods.”
This guidance has accelerated RMM adoption in EM, especially in aseptic processing facilities where real-time microbial monitoring directly supports a proactive contamination control strategy (CCS).
How RMM Works: Technologies and Mechanisms
RMM encompasses several scientific principles. Depending on the technology, it may detect whole cells, nucleic acids, cellular metabolites, or even microbial-induced changes in physical properties.
1. ATP Bioluminescence
This method measures adenosine triphosphate (ATP) — the universal energy molecule present in all living cells. When ATP reacts with luciferase and luciferin, light is emitted and measured by a luminometer. The intensity of light correlates with biological contamination.
- Application: Surface and equipment hygiene monitoring
- Advantage: Immediate results (within seconds to minutes)
- Limitation: Cannot distinguish between microbial and non-microbial ATP
2. Flow Cytometry
Flow cytometers use fluorescent staining and laser-based detection to count and differentiate live/dead microorganisms in a liquid sample.
- Application: Water system and bioburden monitoring
- Advantage: Rapid enumeration, high sensitivity
- Limitation: Interpretation requires expertise and validated calibration
3. Solid-Phase Cytometry
This method filters microorganisms from a liquid sample onto a membrane and uses laser scanning to detect fluorescently labelled cells. It’s widely used for sterility and EM air monitoring applications.
- Application: Air and surface samples in cleanrooms
- Advantage: Detects individual viable cells, even at very low concentrations
- Limitation: High capital investment and operational expertise required
4. qPCR (Quantitative Polymerase Chain Reaction)
qPCR detects and quantifies microbial DNA or RNA by amplifying specific genetic sequences.
- Application: Rapid microbial identification and confirmation
- Advantage: Highly specific and fast (results in a few hours)
- Limitation: Cannot differentiate live from dead cells unless coupled with viability dyes
5. Impedance and Growth Curve Analysis
These systems detect changes in the electrical conductivity or pH of a culture medium as microorganisms grow and multiply.
- Application: Replacement for slow incubation-based bioburden tests
- Advantage: Automated detection with digital data output
- Limitation: Still relies on microbial growth, though faster than the manual method
Integrating RMM into Environmental Monitoring Programs
Implementing RMM is not a simple plug-and-play process. It requires careful method validation, equivalence demonstration, and integration with existing EM workflows.
Key steps in RMM implementation:
- Risk and feasibility assessment: Identify which EM applications can benefit from RMM (e.g., air monitoring, water systems).
- Technology selection: Match the RMM principle to the contamination source and desired sensitivity.
- Method validation and equivalency studies: Demonstrate that RMM provides results that are equal to or better than those of conventional methods.
- Data integration: Ensure compatibility with EM software platforms and compliance with 21 CFR Part 11 for audit trails and data integrity.
- Training and change management: Operators must be trained in RMM interpretation and maintenance to ensure reliable data acquisition and ensure the integrity of the system.
Advantages of RMM in Cleanroom EM
The adoption of RMM delivers measurable benefits across the manufacturing lifecycle:
- Faster decision-making: Detect contamination within hours instead of days, allowing immediate corrective action.
- Reduced production delays: Faster environmental release supports real-time manufacturing and reduces hold times.
- Enhanced contamination control: Continuous or at-line monitoring enables earlier identification of trends.
- Improved data integrity: Digital, automated capture reduces transcription errors and supports traceability.
- Resource optimization: Decreases the need for incubators, manual colony counting, and physical plate handling.
These advantages align perfectly with the Quality by Design (QbD) and Process Analytical Technology (PAT) frameworks, emphasizing in-process control and continuous assurance of product quality.
Common Challenges and Industry Barriers
Despite its advantages, RMM adoption faces practical and cultural hurdles:
- Regulatory caution: Some firms hesitate due to the perceived complexity of validation and regulatory approval.
- Cost of implementation: Initial investment and qualification costs can be significant, particularly for smaller facilities.
- Data comparability: Demonstrating equivalence between legacy and RMM methods is often time-consuming.
- Change management: Integrating RMM into existing SOPs, LIMS systems, and EM trending programs requires a structured project management approach.
However, the industry trend is clear, as regulators increasingly recognize RMM as compliant and advantageous, these barriers are gradually diminishing.
The Future of EM: Toward Real-Time Microbial Surveillance
Next-generation RMM platforms are evolving toward real-time and continuous monitoring, integrating with IoT-based cleanroom management systems.
Emerging technologies include:
- Optical biosensors capable of detecting airborne microorganisms in real time.
- AI-driven image recognition for automated microbial colony identification.
- Miniaturized, self-calibrating systems integrated into HVAC ducts or isolator walls for continuous surveillance.
As pharmaceutical manufacturing moves toward digitalized, closed, and automated environments, RMM will be the backbone of proactive contamination control, providing predictive insights instead of retrospective results.
Conclusion
Rapid Microbiological Methods are transforming how environmental monitoring is conducted in pharmaceutical cleanrooms. By reducing result timelines from days to hours, enhancing compliance through electronic data integrity, and enabling proactive contamination control, RMM technologies align perfectly with the principles of modern aseptic manufacturing and regulatory expectations under Annex 1 and 21 CFR Part 11.
While validation and integration pose challenges, the shift toward rapid, data-driven EM is inevitable, and facilities that adopt early stand to gain not only faster batch release but also a stronger, more resilient contamination control strategy.
FAQs
1. What are Rapid Microbiological Methods (RMM)?
RMM are technologies that accelerate the detection and quantification of microorganisms compared to traditional culture-based methods, offering faster and more automated results.
2. How are RMM used in environmental monitoring (EM)?
They are used for air, surface, and water monitoring to quickly identify microbial contamination and support faster decision-making in cleanrooms.
3. Are RMM systems compliant with Annex 1 and 21 CFR Part 11?
Yes, when validated properly. These systems are encouraged by regulators to enhance contamination control and data integrity.
4. What are the main benefits of RMM in pharma cleanrooms?
They enable faster results, improved contamination control, and digital traceability — reducing downtime and manual handling errors.
5. What is the future of RMM in EM?
RMM will evolve toward continuous, real-time monitoring integrated with digital cleanroom systems and AI-driven data analysis.




